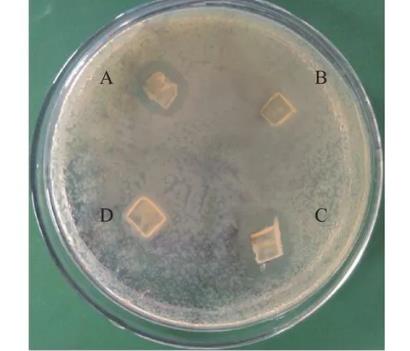
豨薟草果實內生細菌分離、鑒定、生長特性、抑菌效果及藥敏分析（二）
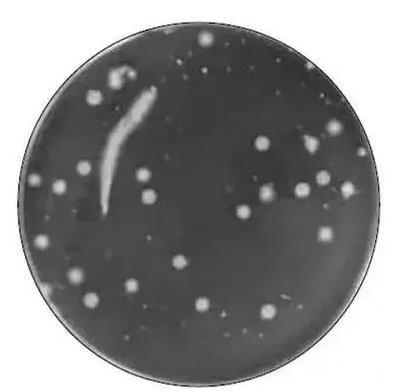
?菌落計數儀的計數和培養步驟、稀釋標準及注意事項

內生細菌在適宜生境中能通過發酵獲得大量目的活性產物,從而可以緩解某些藥用植物資源短缺、生長周期長、生態系統損害等現象,并能為新藥開發與瀕危藥用植物保護 ...
歡迎來到BioSense網站!
歡迎來到BioSense網站!
內生細菌在適宜生境中能通過發酵獲得大量目的活性產物,從而可以緩解某些藥用植物資源短缺、生長周期長、生態系統損害等現象,并能為新藥開發與瀕危藥用植物保護 ...

本研究以豨薟草中篩選分離得到的具有抗感染活性的內生細菌菌株為研究對象,并闡述其相關生物學特性,旨在為進一步研究該菌株的抗感染代謝產物提供理論依據。 ...

?通過對原料乳細菌數量采用顯微鏡直接細菌計數方法和國標GB478.2-2010菌落總數測定方法進行比較實驗,確定了顯微鏡直接細菌計數方法和國標GB47 ...

試驗結果表明傳統釀造體系的優勢真菌為釀酒酵母和紅曲霉,其中紅曲霉在發酵前3 d占優勢,之后其菌量逐漸下降,而釀酒酵母在發酵第3天后逐漸增加,并隨著發酵 ...

為探明紅曲黃酒釀造過程中紅曲霉的主要抑制因素,本研究將采用分子生態學PCR-DGGE技術及實時熒光定量PCR技術相結合的方法,對平湖紅曲黃酒釀造過程中 ...

在0~24 d貯藏期間,普通包裝、氣調包裝和真空包裝清蒸大黃魚菌落總數均呈增長趨勢(表2),在24 d達到最高點,但均低于規定的限值(50 000 C ...

貯藏過程中清蒸大黃魚魚肉持水力下降使汁液流失,進而導致外觀品質下降,失去的水溶性營養素和風味物質還會成為微生物良好的培養基,促進微生物生長。 ...

本研究通過測定清蒸大黃魚的汁液流失率、pH值、總揮發性鹽基氮(total volatile basic nitrogen,TVB-N)含量、硫代巴比妥 ...

枯草芽孢桿菌為革蘭氏陽性桿菌,呈短桿狀或鏈狀排列,在營養不足或其他壓力條件下,枯草芽孢桿菌會形成芽孢。芽孢一般呈橢圓形,位于細胞的一端或中央,具有較高 ...
菌落形成單位CFU(colony forming unit)用來估算固體或液體樣品中存活的細菌或真菌細胞數量的單位,通常以CFU/g或CFU/mL的形 ...